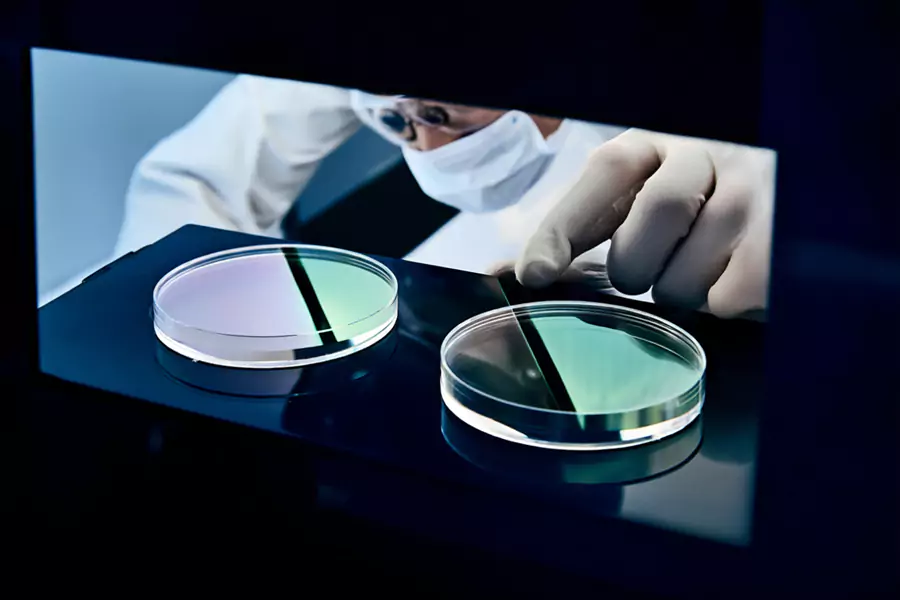
Kuvars Gözetleme Camı Nedir ve Endüstriyel Uygulamalara Nasıl Fayda Sağlar?

Kuvars Gözetleme Camı Nedir ve Endüstriyel Uygulamalara Nasıl Fayda Sağlar?
Kuvars Gözetleme Camı, yüksek sıcaklık, yüksek basınç ve kimyasal olarak zorlu endüstriyel uygulamalarda kullanılan temel bir malzemedir. Benzersiz optik özellikler sağlar
Kuvars Gözetleme Camı, yüksek sıcaklık, yüksek basınç ve kimyasal olarak zorlu endüstriyel uygulamalarda kullanılan temel bir malzemedir. Benzersiz optik özellikler sağlar

Hassas endüstrilerde, doğru malzemeyi seçmek optimum performans için çok önemlidir. Eşsiz özellikleri ile bilinen erimiş kuvars kavisli plakalar

UV engelleyici kuvars tüplerin seçilmesi, dalga boyu, geometri ve bütçeye göre şekillenen bir mühendislik zorluğu sunar. 2025'teki mühendisler, kesimi hizalamalıdır

Doğru kuvars bileşeninin seçilmesi kritik bir mühendislik sorunudur. Her yanlış seçim sistemin ömrünü kısaltır ve maliyetleri artırır. A

Endüstriyel sistemlerde doğru tüp malzemesinin seçilmesi büyük bir zorluk teşkil etmektedir. Her iki ucu açık opak kuvars tüpler

Yüksek sıcaklık uygulamalarında güvenilir ve verimli ısıtma çözümlerine olan talep tüm sektörlerde artmaktadır. Kompakt spiral opak kuvars tüpler

Laboratuvarınız veya endüstriyel uygulamalarınız için doğru konektör topraklama bağlantısı kuvars tüpünü seçmek karmaşık bir karar olabilir. Bu nedenle

2025'in hızla gelişen endüstriyel ortamında, kuvars sindirim tüpleri gibi yüksek performanslı malzemelere olan talep giderek artıyor. Bunlar

Yüksek hassasiyetli uygulamalar için kuvars cam redüktör tüplerini seçerken, benzersiz özelliklerini anlamak optimum performans için çok önemlidir. Kuvars cam
TOQUARTZ, laboratuvar, endüstriyel ve optik mükemmellik için tasarlanmış hassas özelleştirilmiş kuvars cam ürünlerine öncülük etmiştir.
Hızlı prototipleme ile eşleştirilmiş, MOQ kısıtlamaları olmaksızın en iyi kuvars ürünlerini tedarik ediyoruz.
Sorularınız İçin Bize Ulaşın!
Telefon: +86-19311583352
Whatsapp: +86-19311583352
E-posta: info@toquartz.com
TOQUARTZ: Kuvars Cam Çözümü
Genellikle dakikalar içinde yanıt verir
Merhaba, Ben Haber Ma, TOQUARTZ™'da Ürün Mühendisi, Size Nasıl Yardımcı Olabilirim?
WhatsApp Bize
🟢 Çevrimiçi | Gizlilik politikası
Bize neye ihtiyacınız olduğunu söyleyin - 6 saat içinde size özel fiyatlandırma ve teslim süresi alın.
* Gönderdikten sonra e-postayı kontrol edin. Alınmadı mı? Adresi doğrulayın.